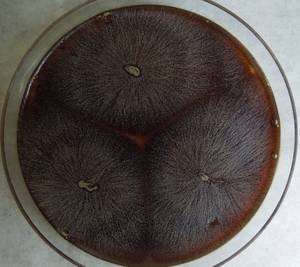
MSU_FS-03360_01, Район Манг Занг (Mang Yang districts), Gia Lai province (Vietnam)

Total items: 2
Total pages: 1
Organisms

- Specimen ID
- 0000001190092
- Species
- Gliocephalotrichum simplex
- Strain
- MSU_FS-03499
- Place of isolation
- Район Манг Занг (Mang Yang districts), Gia Lai province (Vietnam)
- Placename
- Адзун (A Yun commune)
- Specimen ID
- 0000001189900
- Species
- Gliocephalotrichum simplex
- Strain
- MSU_FS-03360
- Place of isolation
- Район Манг Занг (Mang Yang districts), Gia Lai province (Vietnam)
- Placename
- Адзун (A Yun commune)